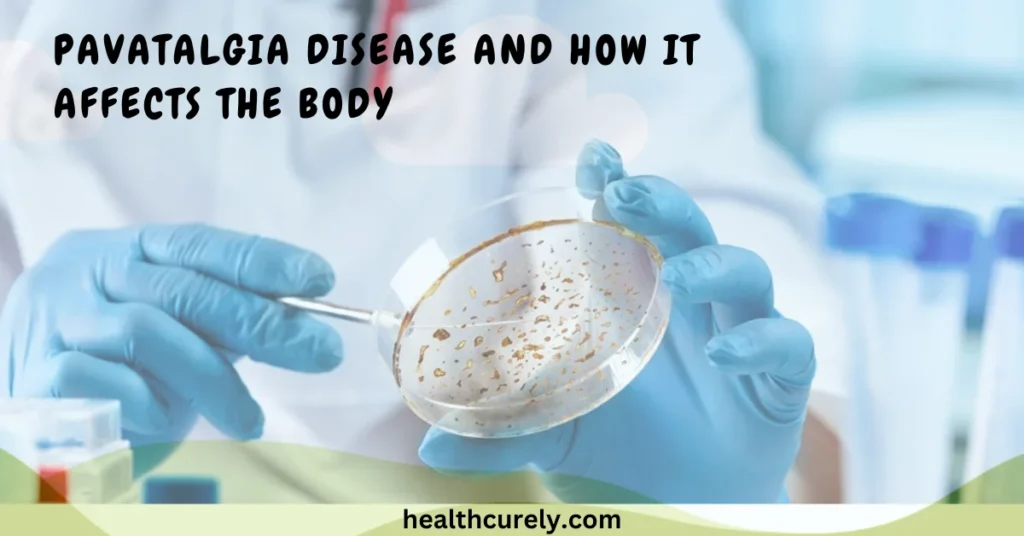
Pavatalgia Disease and How It Affects the Body

Posted inDisease
What Disease Does Sam Elliott Have? Separating Facts From Fiction
If you have been searching for answers to what disease does Sam Elliott have, you are not alone. Millions of fans have typed the same question after stumbling across alarming…